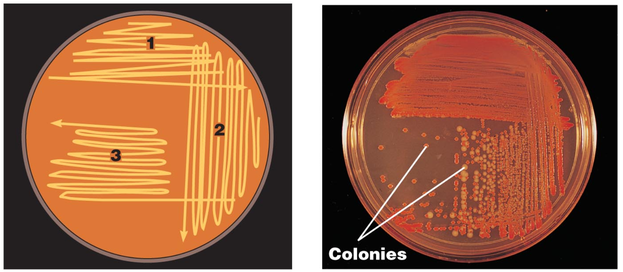
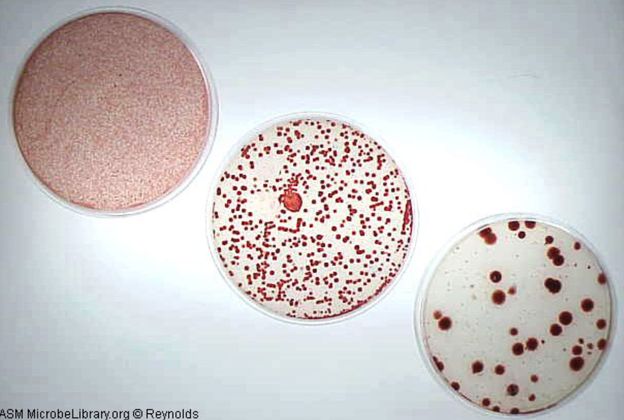

Лекция. Бактериологический метод диагностики (831005)
Текст из файла
Бактериологический метод диагностики
1 этап. Посев исследуемого материала на питательные среды
Важным этапом бактериологического исследования является посев. В зависимости от цели исследования, характера посевного материала и среды используют разные методы посева. Все они включают обязательную цель: оградить посев от посторонних микробов.
Посев из пробирки в пробирку. Пробирку с посевным материалом и пробирку со средой держат слегка наклонно в левой руке между большими и указательными пальцами так, чтобы края пробирок были на одном уровне, а их основания находились поверх кисти. Вынув пробки, края пробирки обжигают в пламени спиртовки. Прокаленную петлю вводят в пробирку с посевным материалом, охлаждают и, набрав немного материала, переносят в пробирку со средой. После посева петлю извлекают из пробирки, края пробирок обжигают и, проведя пробки через пламя спиртовки, закрывают пробирки, после чего прокаливают петлю.
При посеве на жидкие среды тампоном его погружают в среду и 3-5 секунд ополаскивают в ней.
Посев петлей. Небольшое количество посевного материала втирают петлей в поверхность среды у края чашки, несколько раз проводя петлей из стороны в сторону. Затем у того места, где закончились штрихи, агар прокалывают петлей, снимая избыток посевного материала. Оставшийся на петле посевной материал зигзагообразными движениями распределяют по всей поверхности среды. По окончании посева закрывают чашку и прожигают петлю.
Посев тампоном. Тампон с посевным материалом вносят в слегка приоткрытую чашку и круговыми движениями втирают его содержимое в поверхность среды. Засеянные чашки подписывают со стороны дна и помещают в термостат дном вверх.
Метод секторных посевов. Петлей диаметром 2мм, емкостью 0,005 мл, производят посев материала (30-40 штрихов) на сектор А чашки Петри с питательным агаром. После этого петлю прожигают и производят 4 штриховых посева из сектора А в сектор I и аналогичным образом - из сектора I во II и из II в III. Чашки инкубируют при 37 С 18-24 часа, затем подсчитывают число колонии, выросших в разных секторах.
Метод секторных посевов используется при исследовании мочи. Определение степени бактериурии, по количеству выросших колонии, производят согласно таблице. Данный метод позволяет не только определить степень бактериурии, но и выделить возбудителя заболевания в чистой культуре.
Степень бактериурии позволяет дифференцировать инфекционный процесс в мочевых путях от контаминации мочи нормальной микрофлорой. С этой целью используют следующие критерии:
1. Степень бактериурии, не превышающая 103 микробных клеток в 1 мл мочи, свидетельствует об отсутствии воспалительного процесса и обычно является результатом контаминации мочи.
2. Степень бактериурии, равная 104 микробных клеток в 1 мл мочи, расценивается как сомнительный результат. Исследование следует повторить.
3. Степень бактериурии, равная и выше 105 микробных клеток в 1 мл мочи, указывает на наличие воспалительного процесса.
2 ЭТАП. Выделение чистой культуры возбудителя заболевания.
Чистая культура – содержит микроорганизмы одного вида и полученные как потомство одной клетки.
· Метод Дригальского - метод изолированных колоний, используется для культур, растущих на плотных питательных средах.
Исследуемую колонию равномерно распределяют при помощи стерильного шпателя по поверхности питательной среды в 1-ой чашке. Потом, не прожигая шпатель на огне, делают им же посев на 2-ой и 3-ей чаше. Суть метода Дригальского заключается в том, что с каждым последующим посевом культур концентрация бактерий (аэробов) все меньше. На 3-ей чашке они распределяются довольно обособленно, каждая бактериальная клетка при этом дает клональные клетки (в виде изолированной колонии).
Вместо шпателя можно пользоваться петлей. Материал на питательной среде распределяют по ½ чашке параллельными штрихами, затем повернув чашку на 90 градусов проводят штрихи в направлении перпендикулярном первым штрихам
·Метод Коха - метод серийных разведений, используется для культур, не растущих на плотных питательных средах.
Три пробирки, содержащие 15 мл расплавленного МПА. В первую пробирку вносят одну бактериологическую петлю исследуемого материала. После этого одну петлю содержимого первой пробирки переносят во вторую и таким же образом из второй в третью. Приготовленные разведения выливают из пробирок в стерильные чашки Петри.
Количество колоний в чашках с питательной средой уменьшается по мере разведения материала.
· Метод Шукевича - используется для микроорганизмов дающих ползучий рост (роение).
3 ЭТАП. Идентификация выделенного возбудителя заболевания.
Определение вида возбудителя заболевания из материала больного проводят по следующим признакам:
1. По морфологии возбудителя (из чистой культуры готовят мазки, окрашивают и микроскопируют).
2. По культуральным свойствам (характеру роста на питательных средах.).
3. По биохимической активности:
Сахаролитическая активность - разложение углеводов и многоатомньгх спиртов до кислоты (К) - изменение цвета индикатора, или до кислоты и газа (КГ) - изменение цвета индикатора и образование пузырьков газа. Сахаролитическую активность изучают на средах Гисса, которые содержат тот или иной углевод, многоатомный спирт и индикатор.
Протеолитическая активность - способность разлагать белки с образованием аммиака (лакмусовая бумажка синеет); сероводорода - сеют микроорганизм на пептонную воду и под пробку вносят индикаторную бумажку, пропитанную уксусно-кислым свинцом - при выделении сероводорода бумажка чернеет; индола - сеют культуру на мясо-пептонный бульон, под пробирку вносят индикаторную бумажку, пропитанную щавелевой кислотой - при выделении индола бумажка розовеет.
Способы изучения биохимических свойств бактерий:
А). Среды «пестрого ряда» (среды Гисса).
Б). Система индикаторных бумаг (СИБы).
Состав: диски из фильтровальной бумаги, пропитанные питательными средствами (питательная основа + субстрат + индикатор) и высушенные, хранятся во флаконах.
Принцип действия: диски добавляются к густой суспензии исследуемой культуры в физрастворе. Учет производят после 18-24 часовой инкубации в термостате по изменению цвета индикатора.
В). Панели биохимической идентификации.
Состав: в лунках специальных пластиковых панелей находятся соответствующие высушенные питательные среды (питательная основа + субстрат + индикатор).
Принцип действия: в лунки вносят суспензию исследуемой культуры и после инкубации (от 5 до 24 часов) учитывают результат по изменению цвета индикатора.
Г). Системы автоматизированной идентификации.
Принцип действия тот же, что и в предыдущем методе, однако инкубация панелей, учет результатов и идентификация производится при помощи компьютера.
4. По антигенной структуре: постановка реакции агглютинации (РА) на стекле с агглютинирующими сыворотками.
5. Фаготипаж: определение вида возбудителя по заведомо известному бактериофагу (вирус бактерий) методами: стерильного пятна и просветления бульона.
6. По признакам патогенности: определение токсигенности культуры (в реакции преципитации в агаре (ПР); в реакции нейтрализации на животных (РН). По ферментам патогенности (лецитоветиллаза, плазмокоагулаза). Антифагины - капсула при микроскопировании.
Характеристики
Тип файла документ
Документы такого типа открываются такими программами, как Microsoft Office Word на компьютерах Windows, Apple Pages на компьютерах Mac, Open Office - бесплатная альтернатива на различных платформах, в том числе Linux. Наиболее простым и современным решением будут Google документы, так как открываются онлайн без скачивания прямо в браузере на любой платформе. Существуют российские качественные аналоги, например от Яндекса.
Будьте внимательны на мобильных устройствах, так как там используются упрощённый функционал даже в официальном приложении от Microsoft, поэтому для просмотра скачивайте PDF-версию. А если нужно редактировать файл, то используйте оригинальный файл.
Файлы такого типа обычно разбиты на страницы, а текст может быть форматированным (жирный, курсив, выбор шрифта, таблицы и т.п.), а также в него можно добавлять изображения. Формат идеально подходит для рефератов, докладов и РПЗ курсовых проектов, которые необходимо распечатать. Кстати перед печатью также сохраняйте файл в PDF, так как принтер может начудить со шрифтами.